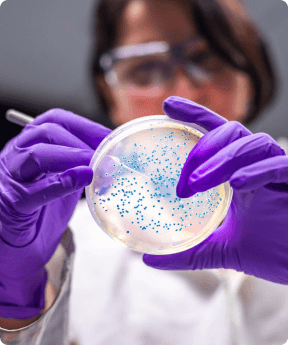
Experiment

BIMINI LABS
ULTIMATE NAD +
BOOSTER
FOY is the ultimate NAD+ boosting supplement for enhanced athletic performance and optimal health.
Get Started


The Science Behind FOY
FOY – Lifespan Formula contains a powerful blend of natural ingredients that have been scientifically proven to boost NAD+ levels, improve athletic performance, and fight the effects of aging. Discover the science behind FOY and learn how it can help you achieve peak performance and optimal health.
Learn MoreIngredients and Benefits


Are you ready to start feeling younger?
BIMINI LABS
What We Do
At Bimini Labs, we are dedicated to creating cutting-edge supplements that are backed by science and clinical studies. Our team of experts is committed to staying at the forefront of the latest research and trends in the industry.
We believe in the power of nature and strive to use natural ingredients whenever possible to support optimal health and well-being.


Frequently Asked Questions
FOY – Lifespan Formula is a powerful NAD+ booster that contains a unique blend of ingredients specifically formulated to reduce the aging process and improve overall health by combating the issues that come along with aging…
Results may vary, but many users of FOY report feeling increased energy levels, improved mental clarity, and faster muscle recovery within 14 days of use.
FOY – Lifespan Formula is a dietary supplement, not a drug. It uses natural ingredients like Berberine and Ginger Root Extract instead of FDA-controlled substances like Metformin and Aspirin…
FOY – Lifespan Formula is USADA compliant and has been tested to ensure that it does not contain any banned substances.
We use only high-quality, pure ingredients in FOY – Lifespan Formula and source them from trusted suppliers. Our manufacturing process is strictly regulated for purity and effectiveness.
BIMINI LABS
ULTIMATE NAD +
BOOSTER
FOY is the ultimate NAD+ boosting supplement for enhanced athletic performance and optimal health.
Get Started


The Science Behind FOY
FOY – Lifespan Formula contains a powerful blend of natural ingredients that have been scientifically proven to boost NAD+ levels, improve athletic performance, and fight the effects of aging. Discover the science behind FOY and learn how it can help you achieve peak performance and optimal health.
Learn MoreIngredients and Benefits


Are you ready to start feeling younger?
BIMINI LABS
What We Do
At Bimini Labs, we are dedicated to creating cutting-edge supplements that are backed by science and clinical studies. Our team of experts is committed to staying at the forefront of the latest research and trends in the industry.
We believe in the power of nature and strive to use natural ingredients whenever possible to support optimal health and well-being.


Partner Program Umbrella
Frequently Asked Questions
-
FOY – Lifespan Formula is a powerful NAD+ booster that contains a unique blend of ingredients specifically formulated to reduce the aging process and improve overall health by combating the issues that come along with aging. NAD+ (nicotinamide adenine dinucleotide) is a coenzyme found in every cell of the body that plays a vital role in metabolism, DNA repair, and energy production. As we age, NAD+ levels naturally decline, leading to a decrease in energy and an increase in the effects of aging.
FOY – Lifespan Formula contains ingredients like Beta-Nicotinamide Mononucleotide (β-NMN), Resveratrol, Trimethylglycine, Berberine, Ginger Root Extract, Vitamin K2, and Vitamin D3 all of which have been shown to boost NAD+ levels, improve mitochondrial function, and increase energy production in the body. This specific formula was actually created (and taken daily) by Harvard doctor David Sinclair who is at the forefront of this industry. While developed as an anti-aging formula, the range of benefits for athletes including; increased energy levels, improved reaction times, enhanced muscle development, faster muscle recovery, reduced fatigue, and improved mental clarity and mood are undeniable. In addition, the anti-inflammatory properties of FOY may help reduce muscle soreness and improve post-workout repair. Overall, FOY is an effective and natural way for athletes to improve their performance and fight the effects of aging.
-
Results may vary, but many users of FOY report feeling increased energy levels, improved mental clarity, and faster muscle recovery within 14 days of use.
-
FOY – Lifespan Formula is a dietary supplement, not a drug. As such, it does not contain any FDA-controlled substances like Metformin or Aspirin. Instead, FOY – Lifespan Formula uses natural ingredients like Berberine and Ginger Root Extract to support overall health and improve athletic performance. These ingredients were carefully selected as effective alternatives to Metformin and Aspirin, as clinical trials of each have time and again proven to be just as efficient (if not more) than their drug counterpart.
Berberine HCI is an alkaloid compound found in plants like Berberis aristata and Hydrastis canadensis. It has a long history of use in traditional medicine and has been shown to have a range of health benefits, including supporting healthy glucose metabolism, improving cardiovascular health, and reducing inflammation. Several studies have demonstrated the effectiveness of Berberine HCI in improving various markers of health and wellness (1, 2). In comparison, Metformin is a prescription medication that is commonly used to treat type 2 diabetes. It works by decreasing the amount of sugar produced by the liver and increasing the sensitivity of muscle cells to insulin. While both Berberine HCI and Metformin can help support healthy glucose metabolism, Berberine HCI is a natural alternative that may have fewer side effects.
Ginger Root Extract is another natural ingredient in FOY – Lifespan Formula. Ginger has been used for over 2,000 years as a natural remedy for a variety of health conditions and is known for its anti-inflammatory and antioxidant properties. Studies have shown that ginger can help reduce muscle soreness, improve exercise performance, and support cardiovascular health (3, 4). In comparison, Aspirin is a nonsteroidal anti-inflammatory drug (NSAID) that is commonly used to reduce pain and inflammation. While both Ginger Root Extract and Aspirin can help reduce inflammation, Ginger Root Extract is a natural alternative that may have fewer gastrointestinal side effects.
References:
https://www.ncbi.nlm.nih.gov/pmc/articles/PMC6222734/
https://www.ncbi.nlm.nih.gov/pmc/articles/PMC5357672/
https://www.ncbi.nlm.nih.gov/pmc/articles/PMC3550262/
https://www.ncbi.nlm.nih.gov/pmc/articles/PMC3665023/ -
FOY – Lifespan Formula is USADA compliant and has been tested to ensure that it does not contain any banned substances.
-
We use only high-quality, pure ingredients in FOY – Lifespan Formula and source them from trusted suppliers. Our manufacturing process is also strictly regulated to ensure the purity and effectiveness of the product.
FOY – Lifespan Formula is a powerful NAD+ booster that contains a unique blend of ingredients specifically formulated to reduce the aging process and improve overall health by combating the issues that come along with aging. NAD+ (nicotinamide adenine dinucleotide) is a coenzyme found in every cell of the body that plays a vital role in metabolism, DNA repair, and energy production. As we age, NAD+ levels naturally decline, leading to a decrease in energy and an increase in the effects of aging.
FOY – Lifespan Formula contains ingredients like Beta-Nicotinamide Mononucleotide (β-NMN), Resveratrol, Trimethylglycine, Berberine, Ginger Root Extract, Vitamin K2, and Vitamin D3 all of which have been shown to boost NAD+ levels, improve mitochondrial function, and increase energy production in the body. This specific formula was actually created (and taken daily) by Harvard doctor David Sinclair who is at the forefront of this industry. While developed as an anti-aging formula, the range of benefits for athletes including; increased energy levels, improved reaction times, enhanced muscle development, faster muscle recovery, reduced fatigue, and improved mental clarity and mood are undeniable. In addition, the anti-inflammatory properties of FOY may help reduce muscle soreness and improve post-workout repair. Overall, FOY is an effective and natural way for athletes to improve their performance and fight the effects of aging.
Results may vary, but many users of FOY report feeling increased energy levels, improved mental clarity, and faster muscle recovery within 14 days of use.
FOY – Lifespan Formula is a dietary supplement, not a drug. As such, it does not contain any FDA-controlled substances like Metformin or Aspirin. Instead, FOY – Lifespan Formula uses natural ingredients like Berberine and Ginger Root Extract to support overall health and improve athletic performance. These ingredients were carefully selected as effective alternatives to Metformin and Aspirin, as clinical trials of each have time and again proven to be just as efficient (if not more) than their drug counterpart.
Berberine HCI is an alkaloid compound found in plants like Berberis aristata and Hydrastis canadensis. It has a long history of use in traditional medicine and has been shown to have a range of health benefits, including supporting healthy glucose metabolism, improving cardiovascular health, and reducing inflammation. Several studies have demonstrated the effectiveness of Berberine HCI in improving various markers of health and wellness (1, 2). In comparison, Metformin is a prescription medication that is commonly used to treat type 2 diabetes. It works by decreasing the amount of sugar produced by the liver and increasing the sensitivity of muscle cells to insulin. While both Berberine HCI and Metformin can help support healthy glucose metabolism, Berberine HCI is a natural alternative that may have fewer side effects.
Ginger Root Extract is another natural ingredient in FOY – Lifespan Formula. Ginger has been used for over 2,000 years as a natural remedy for a variety of health conditions and is known for its anti-inflammatory and antioxidant properties. Studies have shown that ginger can help reduce muscle soreness, improve exercise performance, and support cardiovascular health (3, 4). In comparison, Aspirin is a nonsteroidal anti-inflammatory drug (NSAID) that is commonly used to reduce pain and inflammation. While both Ginger Root Extract and Aspirin can help reduce inflammation, Ginger Root Extract is a natural alternative that may have fewer gastrointestinal side effects.
References:
https://www.ncbi.nlm.nih.gov/pmc/articles/PMC6222734/
https://www.ncbi.nlm.nih.gov/pmc/articles/PMC5357672/
https://www.ncbi.nlm.nih.gov/pmc/articles/PMC3550262/
https://www.ncbi.nlm.nih.gov/pmc/articles/PMC3665023/
FOY – Lifespan Formula is USADA compliant and has been tested to ensure that it does not contain any banned substances.
We use only high-quality, pure ingredients in FOY – Lifespan Formula and source them from trusted suppliers. Our manufacturing process is also strictly regulated to ensure the purity and effectiveness of the product.
BIMINI LABS
ULTIMATE NAD +
BOOSTER
FOY is the ultimate NAD+ boosting supplement for enhanced athletic performance and optimal health.
Get Started


The Science Behind FOY
FOY – Lifespan Formula contains a powerful blend of natural ingredients that have been scientifically proven to boost NAD+ levels, improve athletic performance, and fight the effects of aging. Discover the science behind FOY and learn how it can help you achieve peak performance and optimal health.
Learn MoreIngredients and Benefits


Are you ready to start feeling younger?
BIMINI LABS
What We Do
At Bimini Labs, we are dedicated to creating cutting-edge supplements that are backed by science and clinical studies. Our team of experts is committed to staying at the forefront of the latest research and trends in the industry.
We believe in the power of nature and strive to use natural ingredients whenever possible to support optimal health and well-being.

Partner Program Umbrella
Frequently Asked Questions
-
FOY – Lifespan Formula is a powerful NAD+ booster that contains a unique blend of ingredients specifically formulated to reduce the aging process and improve overall health by combating the issues that come along with aging. NAD+ (nicotinamide adenine dinucleotide) is a coenzyme found in every cell of the body that plays a vital role in metabolism, DNA repair, and energy production. As we age, NAD+ levels naturally decline, leading to a decrease in energy and an increase in the effects of aging.
FOY – Lifespan Formula contains ingredients like Beta-Nicotinamide Mononucleotide (β-NMN), Resveratrol, Trimethylglycine, Berberine, Ginger Root Extract, Vitamin K2, and Vitamin D3 all of which have been shown to boost NAD+ levels, improve mitochondrial function, and increase energy production in the body. This specific formula was actually created (and taken daily) by Harvard doctor David Sinclair who is at the forefront of this industry. While developed as an anti-aging formula, the range of benefits for athletes including; increased energy levels, improved reaction times, enhanced muscle development, faster muscle recovery, reduced fatigue, and improved mental clarity and mood are undeniable. In addition, the anti-inflammatory properties of FOY may help reduce muscle soreness and improve post-workout repair. Overall, FOY is an effective and natural way for athletes to improve their performance and fight the effects of aging.
-
Results may vary, but many users of FOY report feeling increased energy levels, improved mental clarity, and faster muscle recovery within 14 days of use.
-
FOY – Lifespan Formula is a dietary supplement, not a drug. As such, it does not contain any FDA-controlled substances like Metformin or Aspirin. Instead, FOY – Lifespan Formula uses natural ingredients like Berberine and Ginger Root Extract to support overall health and improve athletic performance. These ingredients were carefully selected as effective alternatives to Metformin and Aspirin, as clinical trials of each have time and again proven to be just as efficient (if not more) than their drug counterpart.
Berberine HCI is an alkaloid compound found in plants like Berberis aristata and Hydrastis canadensis. It has a long history of use in traditional medicine and has been shown to have a range of health benefits, including supporting healthy glucose metabolism, improving cardiovascular health, and reducing inflammation. Several studies have demonstrated the effectiveness of Berberine HCI in improving various markers of health and wellness (1, 2). In comparison, Metformin is a prescription medication that is commonly used to treat type 2 diabetes. It works by decreasing the amount of sugar produced by the liver and increasing the sensitivity of muscle cells to insulin. While both Berberine HCI and Metformin can help support healthy glucose metabolism, Berberine HCI is a natural alternative that may have fewer side effects.
Ginger Root Extract is another natural ingredient in FOY – Lifespan Formula. Ginger has been used for over 2,000 years as a natural remedy for a variety of health conditions and is known for its anti-inflammatory and antioxidant properties. Studies have shown that ginger can help reduce muscle soreness, improve exercise performance, and support cardiovascular health (3, 4). In comparison, Aspirin is a nonsteroidal anti-inflammatory drug (NSAID) that is commonly used to reduce pain and inflammation. While both Ginger Root Extract and Aspirin can help reduce inflammation, Ginger Root Extract is a natural alternative that may have fewer gastrointestinal side effects.
References:
https://www.ncbi.nlm.nih.gov/pmc/articles/PMC6222734/
https://www.ncbi.nlm.nih.gov/pmc/articles/PMC5357672/
https://www.ncbi.nlm.nih.gov/pmc/articles/PMC3550262/
https://www.ncbi.nlm.nih.gov/pmc/articles/PMC3665023/ -
FOY – Lifespan Formula is USADA compliant and has been tested to ensure that it does not contain any banned substances.
-
We use only high-quality, pure ingredients in FOY – Lifespan Formula and source them from trusted suppliers. Our manufacturing process is also strictly regulated to ensure the purity and effectiveness of the product.
FOY – Lifespan Formula is a powerful NAD+ booster that contains a unique blend of ingredients specifically formulated to reduce the aging process and improve overall health by combating the issues that come along with aging. NAD+ (nicotinamide adenine dinucleotide) is a coenzyme found in every cell of the body that plays a vital role in metabolism, DNA repair, and energy production. As we age, NAD+ levels naturally decline, leading to a decrease in energy and an increase in the effects of aging.
FOY – Lifespan Formula contains ingredients like Beta-Nicotinamide Mononucleotide (β-NMN), Resveratrol, Trimethylglycine, Berberine, Ginger Root Extract, Vitamin K2, and Vitamin D3 all of which have been shown to boost NAD+ levels, improve mitochondrial function, and increase energy production in the body. This specific formula was actually created (and taken daily) by Harvard doctor David Sinclair who is at the forefront of this industry. While developed as an anti-aging formula, the range of benefits for athletes including; increased energy levels, improved reaction times, enhanced muscle development, faster muscle recovery, reduced fatigue, and improved mental clarity and mood are undeniable. In addition, the anti-inflammatory properties of FOY may help reduce muscle soreness and improve post-workout repair. Overall, FOY is an effective and natural way for athletes to improve their performance and fight the effects of aging.
Results may vary, but many users of FOY report feeling increased energy levels, improved mental clarity, and faster muscle recovery within 14 days of use.
FOY – Lifespan Formula is a dietary supplement, not a drug. As such, it does not contain any FDA-controlled substances like Metformin or Aspirin. Instead, FOY – Lifespan Formula uses natural ingredients like Berberine and Ginger Root Extract to support overall health and improve athletic performance. These ingredients were carefully selected as effective alternatives to Metformin and Aspirin, as clinical trials of each have time and again proven to be just as efficient (if not more) than their drug counterpart.
Berberine HCI is an alkaloid compound found in plants like Berberis aristata and Hydrastis canadensis. It has a long history of use in traditional medicine and has been shown to have a range of health benefits, including supporting healthy glucose metabolism, improving cardiovascular health, and reducing inflammation. Several studies have demonstrated the effectiveness of Berberine HCI in improving various markers of health and wellness (1, 2). In comparison, Metformin is a prescription medication that is commonly used to treat type 2 diabetes. It works by decreasing the amount of sugar produced by the liver and increasing the sensitivity of muscle cells to insulin. While both Berberine HCI and Metformin can help support healthy glucose metabolism, Berberine HCI is a natural alternative that may have fewer side effects.
Ginger Root Extract is another natural ingredient in FOY – Lifespan Formula. Ginger has been used for over 2,000 years as a natural remedy for a variety of health conditions and is known for its anti-inflammatory and antioxidant properties. Studies have shown that ginger can help reduce muscle soreness, improve exercise performance, and support cardiovascular health (3, 4). In comparison, Aspirin is a nonsteroidal anti-inflammatory drug (NSAID) that is commonly used to reduce pain and inflammation. While both Ginger Root Extract and Aspirin can help reduce inflammation, Ginger Root Extract is a natural alternative that may have fewer gastrointestinal side effects.
References:
https://www.ncbi.nlm.nih.gov/pmc/articles/PMC6222734/
https://www.ncbi.nlm.nih.gov/pmc/articles/PMC5357672/
https://www.ncbi.nlm.nih.gov/pmc/articles/PMC3550262/
https://www.ncbi.nlm.nih.gov/pmc/articles/PMC3665023/
FOY – Lifespan Formula is USADA compliant and has been tested to ensure that it does not contain any banned substances.
We use only high-quality, pure ingredients in FOY – Lifespan Formula and source them from trusted suppliers. Our manufacturing process is also strictly regulated to ensure the purity and effectiveness of the product.
See what these customers have to say

Tumi Vil-Nkomo

May 18, 2024
FOY has been life-changing for me! As a professional dancer for 20+ years, it has taken a toll on my body. Motivating myself to get up and go to rehearsals became a difficult task, and dancing is my passion. That being said, within 2 weeks of taking FOY I felt better than I had in a long time! Waking up pain-free, energized, & feeling strong as ever! FOY USER FOR LIFE!

Dr. M.J. Lambert III

May 03, 2024
About three years ago, my son gave me a copy of David Sinclair’s book, Lifespan. As a physician, I found Sinclair’s ideas and research compelling and began to take both resveratrol and NMN and I feel better in every way both physically and mentally. Recently, I switched to FOY and feel that it is superior to the products I was previously using in every way.

Marcela Caronti

May 07, 2024
First of all, let me be clear… I’d be the first one to tell my husband his product doesn’t work if I wasn’t feeling results. But, that is not the case! I teach Zumba 5-7 times a week on top of a full-time job and being a mom to 3 kids. After taking FOY for near 2 weeks, the next day soreness went away I was able to give a good bit more in my classes! I feel amazing thanks to FOY!







